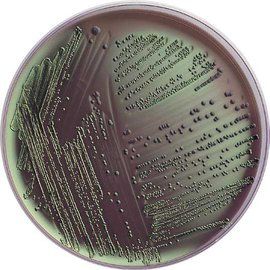
MS培養基

MS培養基
MS是人名Murashige and Skoog的縮寫。
MS培養基是Murashige和Skoog於1962年為菸草細胞培養設計的,其特點是無機鹽和離子濃度較高,是較穩定的離子平衡溶液,它的硝酸鹽含量高,其養分的數量和比例合適,能滿足植物細胞的營養和生理需要,因而適用範圍比較廣,多數植物組織培養快速繁殖用它作為培養基的基本培養基。 基於此,這種培養基就用他們的名字來命名了。
MS培養基是目前使用最普遍的培養基。其具有較高的無機鹽濃度,能夠保證組織生長所需的礦質營養還能加速愈傷組織的生長。由於配方中的離子濃度高,在配製、貯存和消毒等過程中,即使有些成分略有出入,也不會影響離子間的平衡。MS固體培養基可用於誘導愈傷組織,也可用於胚、莖段、莖尖及花葯的培養,其液體培養基用於細胞懸浮培養時能獲得明顯的成功。MS培養基的無機養分的數量和比例比較合適,足以滿足植物細胞在營養上和生理上的需要。因此,一般情況下,不用再添加胺基酸、酪蛋白水解物、酵母提取物及椰子汁等有機附加成分。和其它培養基的基本成分相比,MS培養基中的硝酸鹽、鉀和銨的含量高,這是它的顯著特點。
MS培養基配方表
| 大量元素 成分 | 分子量 | 使用濃度 (mg/L) | |
| 硝酸鉀 KNO3 | 101.21 | 1900 | |
| 硝酸銨 NH4NO3 | 80.04 | 1650 | |
| 磷酸二氫鉀 KH2PO4 | 136.09 | 170 | |
| 硫酸鎂 MgSO4·7H2O | 246.47 | 370 | |
| 氯化鈣 CaCl2·2H2O | 147.02 | 440 | |
| 微量元素 | | | |
| 碘化鉀 KI | 166.01 | 0.83 | |
| 硼酸 H3BO3 | 61.83 | 6.2 | |
| 硫酸錳 MnSO4·4H2O | 223.01 | 22.3 | |
| 硫酸鋅 ZnSO4·7 H2O | 287.54 | 8.6 | |
| 鉬酸鈉 Na2MoO4·2 H2O | 241.95 | 0.25 | |
| 硫酸銅 CuSO4·5 H2O | 249.68 | 0.025 | |
| 氯化鈷 CoCl2·6H2O | 237.93 | 0.025 | |
| 鐵鹽 | | | |
| 乙二胺四乙酸二鈉 Na2.EDTA | 372.25 | 37.25 | |
| 硫酸亞鐵 FeSO24·7H2O | 278.03 | 27.85 | |
| 有機成分 | | | |
| 肌醇 | | 100 | |
| 甘氨酸 | | 2 | |
| 鹽酸硫胺素 VB1 | | 0.1 | |
| 鹽酸吡哆醇 VB6 | | 0.5 | |
| 煙酸 VB5 或 VPP | | 0.5 | |
| | | | |
| 蔗糖 sucrose | 342.31 | 30g /L | |
| | | | |
| 瓊脂 agar | | 7 g /L | |
注意事項
1.母液Ⅱ及母液Ⅳ的配製方法是:每種母液中的幾種成分稱量完畢後,分別用少量的蒸餾水徹底溶解,然後再將它們混溶,最後定容到1 L。
2.母液Ⅲ的配製方法是:將稱好的FeSO4·7H2O和Na2-EDTA·2H2O分別放到450 mL蒸餾水中,邊加熱邊不斷攪拌使它們溶解,然後將兩種溶液混合,並將pH調至5.5,最後定容到1 L,保存在棕色玻璃瓶中。
3.MS培養基中還需要加入2,4-二氯苯氧乙酸(2,4-D)、萘乙酸(NAA)、6 苄基嘌呤(6BA)等植物生長調節物質,並且分別配成母液(0 1 mg/mL)。其配製方法是:分別稱取這3種物質各10 mg,將2,4-D和NAA用少量(1 mL)無水乙醇預溶,將6BA用少量(1 mL)的物質的量濃度為0.1 mol/L的NaOH溶液溶解,溶解過程需要水浴加熱,最後分別定容至100 mL,即得質量濃度為0 1 mg/mL的母液。
4.組織培養是否能夠獲得成功,主要取決於對培養基的選擇。不同的培養基具有不同的特點,也就適合於不同的植物種類和接種材料。在開展組織培養項目時,首先要對各種培養基進行了解和分析,以便能從中選擇合適的使用。組培用的培養基一般包括基礎培養基和激素,但是植物激素的種類和數量,隨著不同培養階段和不同材料有變化,因此各培養基配方中均不列入植物激素。常用的基礎培養基除了有MS培養基,還有B5培養基,N6培養基。